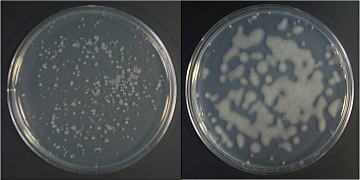
Lipomyces属のコロニー

◆◇◆ ━━━━━━━━━━━━━━━━━━━━━━━━━━━ ◆◇◆
NBRCニュース No. 16(2012.8.1)
◆◇◆ ━━━━━━━━━━━━━━━━━━━━━━━━━━━ ◆◇◆
NBRCニュース第16号をお届けします。今号は、微生物あれこれと微生物の培
養法の2つの連載をお届けします。最後までお読みいただければ幸いです。
(等幅フォントでご覧ください)
======================================================================
内容
======================================================================
1.新たに公開した微生物株(2012年5月19日~7月18日)
2.微生物あれこれ(13)
油脂生産酵母 Lipomyces
3.微生物の培養法(8)
微細藻類の液体培養について
4.お盆期間中のNBRC微生物株・DNAリソースの発送休止について
5.子ども科学センター・ハチラボのお知らせ
6.NITEバイオテクノロジーセンター展示などのお知らせ
======================================================================
1.新たに公開した微生物株(2012年5月19日~7月18日)
======================================================================
糸状菌 43株、細菌 22株、アーキア 1株、微生物ゲノムDNA 3種類を新たに
公開しました。
日本では知らない人はいないであろう秋の味覚マツタケ。今回ご紹介する新
規公開株には、このマツタケTricholoma matsutakeの菌株が多数含まれていま
す。これらの菌株は、アカマツ林内の「シロ」と呼ばれる同一コロニー中に発
生する子実体(キノコ)間でも遺伝的に多様であることを、インターレトロト
ランスポゾン増幅多型解析によって示した論文で使用されたものです。どうぞ
ご利用ください。
Murata H. et al. (2005). Genetic mosaics in the massive persisting
rhizosphere colony “shiro” of the ectomycorrhizal basidiomycete
Tricholoma matsutake. Mycorrhiza 15: 505-512.
【新規公開株一覧】
https://www.nite.go.jp/nbrc/cultures/nbrc/new_strain/new_dna.html
======================================================================
2.微生物あれこれ(13)
油脂生産酵母 Lipomyces (山崎敦史)
======================================================================
脂質を生産し蓄積する微生物の中でも、高い油脂生産能を持つ酵母Lipo-
mycesを紹介します。
Lipomyces属は土壌に生息する子のう菌酵母で、菌体外に大量の多糖を分泌
するため粘液状のコロニーを形成します。一般的な酵母に多いクリーム状コロ
ニーとは大きく異なるため、細菌と見間違えられることもあるようです。これ
までに16種が報告され、無性世代のMyxozyma属を含めると関連種は28種になり
ます。Lipomycesのlipoはlipidに由来しているように、菌体内に油脂を蓄積す
る性質があります。中でもLipomyces starkeyiは、菌体乾燥重量の60~80%に
達する油脂を蓄積します。この特性が注目され、食料や燃料に活用するための
研究が進められています。

Lipomyces属のコロニー(左が培養3日後、右が5日後)
Lipomyces属酵母の生産する油脂は、脂肪酸とグリセリンとで構成されるト
リアシルグリセロール(中性脂質)です。この脂肪酸には50%程度のオレイン
酸、次いで10~30%程度のパルミチン酸やリノール酸、αリノレン酸等が含ま
れます。この脂肪酸組成は、菜種油やオリーブオイル等の植物油脂に類似して
いるため、食用の酵母油としての実用が期待されています。
また、この油脂をバイオディーゼル燃料(BDF)として利用する研究が近年
注目されています。酵母Lipomyces starkeyiと、BDFの原料となる植物(アブ
ラナやアブラヤシ)とで単位面積・時間当たりの油脂生産量を比較すると、酵
母は植物の数千~数万倍効率的に生産できると見積もられており、短期間で大
量のBDF生産が期待できます。さらに、Lipomyces属酵母にはグルコース以外の
糖(キシロースやアラビノース等の五単糖)を利用する能力があります。バイ
オエタノール生産では主にSaccharomyces cerevisiaeによるアルコール発酵が
利用されており、その原料はグルコース(六単糖)です。キシロースやアラビ
ノースは木材にも含まれており、食用にされるグルコースとの競合を避けるこ
とができ、木質系バイオマスを新たなエネルギー資源として新規開拓すること
が可能となります。

脂肪染色液ナイルレッドで染色したLipomyces starkeyi(Bar 50µm)
光学顕微鏡像(左)と蛍光観察像(右)赤く染まっている部分が油脂
このように、Lipomyces属酵母による油脂生産には多くのメリットがありま
す。酵母菌体を破砕して油脂を抽出する操作や酵母残渣の処理などクリアすべ
き課題が残っており、現状としては実用化まで至っていません。しかし、油脂
を菌体外に分泌する酵母株の分離やそのメカニズム解析など、日々精力的な研
究が行われているところです。バイオエタノールに続く新しいバイオ燃料とし
て油脂酵母の活躍が期待されます。
【油脂生産酵母の評価報告】 https://www.nite.go.jp/nbrc/cultures/support/fatyeast.html
======================================================================
3.微生物の培養法(8)
微細藻類の液体培養について (関口弘志)
======================================================================
NBRCでは、微細藻類の大半を液体培養による継代保存で維持しています。今
回は、問い合わせの多い点を中心に、微細藻類の液体培養についての留意点を
紹介します。NBRCニュース第9号では、微細藻類の保存法もご紹介しておりま
すので、ご参照ください。
◇ 培地について
基本的に寄託者が指定した培地を使用しています。ただし、調製が困難で、
かつ、他の培地でも正常に増殖する株については、寄託者と相談の上、変更す
ることもあります。培地は成分に天然物を使用しないものであれば、レシピ通
りに調製を行うことによりトラブルはほとんど発生しませんが、天然物を含む
培地の場合には注意が必要です。代表例としてIMK (SW)培地(NBRC963培地)
があります。NBRCでは、この培地を天然の黒潮海水をベースに調製しています
が、極端に性質の異なる天然海水を使用すると、ごくまれに藻類が増殖不良を
起こしてしまうことがあります。その場合は、人工海水を用いることにより、
良好な増殖が得られます。
NBRCでは2012年5月より微細藻類の発送時に培養用の培地12mL程度を同封し
ておりますので、適宜ご利用ください。
◇ 培養装置(環境)について
従属栄養性の微生物と異なり、藻類を培養するためには光合成のための光環
境を与えることが必要となります。NBRCでは昼光色の3波長型蛍光灯や白色LED
を光源として使用しています。光量は、細胞密度が低い増殖初期には弱光で培
養を行い、細胞の増殖と共に徐々に光量を増やします。光量の調節は調光が可
能な機器であれば問題ないのですが、調光ができない機器の場合には、蛍光灯
の本数を減らすことや培養容器をトレーシングペーパーで覆うなどの対応を行
っています。また、細胞密度が低い状態で強い光条件下で培養を行うと、強光
阻害や光源が発する熱により増殖が極端に悪くなってしまいますので注意が必
要です。この場合、前者への対応としては光量の調節(減光)、後者への対応
としては培養環境の放熱対策をそれぞれ講じる必要があります。

光量の調整と光源の設置例:
(左)トレーシングペーパー(赤矢印)、(中央)上面照射型培養装置(蛍
光灯)、(右)底面照射型培養装置(LED)
◇ 培養容器について
藻類を独立栄養的に培養する際に、ある程度通気性を維持できる容器を使用
すると、良好な増殖を得ることができます。NBRCでは、スクリューキャップ式
の試験管を用いて継代培養を行っていますが、キャップの内側にパッキンが付
属している物は密閉性が高すぎて生育が不安定になる傾向があるため、使用し
ておりません。なお、藻類を発送する際に使用している容器は輸送時の液漏れ
を防ぐために、密閉性の高い容器を使用しております。これは、培養には適し
ませんので、受領されましたら通気性を維持できる容器に移したのち、培養を
行ってください。

(左)振とう培養の様子、(右)発送用試験管
以上が、藻類の液体培養時における留意点となりますが、ご不明な点があれ
ばお気軽にお問い合わせください。
======================================================================
4.お盆期間中のNBRC微生物株・DNAリソースの発送休止について
======================================================================
NBRCでは下記のお盆期間中、送付後の微生物の品質を確保するため、微生物
株・DNAリソースの発送を一時休止させていただきます。
発送休止期間:平成24年8月7日(火)~平成24年8月15日(水)
上記発送休止期間中にお急ぎでご利用になりたい場合は、電話(0438-20-
5763)にてご相談ください。また、発送以外のご依頼・お問合せ等につきまし
ては、通常通り対応させていただいております。ご利用の皆様には、ご不便を
お掛けいたしますが、何卒ご了承いただきますようお願い申し上げます。
【生物遺伝資源の提供・寄託について】 https://www.nite.go.jp/nbrc/cultures/index.html
======================================================================
5.子ども科学センター・ハチラボのお知らせ
======================================================================
「身近な製品を科学する」をメインテーマに、NITEが日頃行っている活動を
皆様に知っていただくため、以下の日程で「子ども科学センター・ハチラボ」
に出展いたします。主に小学生以下のお子様を対象に、NITEの業務に関連した
展示・実験等を行っておりますので、是非お越しください。
日程:2012年8月7日(火)~10月4日(木)10:00~17:00(月曜日閉館)
場所:渋谷区子ども科学センター・ハチラボ
東京都渋谷区桜丘町23-21 文化総合センター大和田3階
https://www.city.shibuya.tokyo.jp/shisetsu/kosodate/hachirabo.html
======================================================================
5.NITEバイオテクノロジーセンター展示などのお知らせ
======================================================================
一般公開や展示についてご紹介します。お立ち寄りいただいた皆様からのご
相談やご質問にもお答えします。是非おこし下さい。
◇ 一般公開
産業技術総合研究所東北センター 一般公開2012
(産業技術総合研究所東北センター主催、NITE東北支所共催)
日程:2012年8月4日(土)
場所:産業技術総合研究所東北センター OSL棟
http://unit.aist.go.jp/tohoku/new/event/20120804.html
◇ 講演会
千葉県バイオ・ライフサイエンス・ネットワーク会議 シーズ発表会
「微生物の産業利用~かずさ発・伝統技術と最新技術の融合~」
日程:2012年9月11日(火)
場所:かずさアカデミアホール(千葉県木更津市)
詳細は追って下記主催者のホームページから案内されます。
http://www.kazusa.or.jp/bio-network/index.html
◇ 展示
2012年度(第27回)日本放線菌学会大会
日程:2012年9月6日(木)~7日(金)
場所:府中の森芸術劇場 (東京都府中市)
http://www.tuat.ac.jp/~saj2012/
日本防菌防黴学会第39回年次大会
日程:2012年9月11日(火)~12日(水)
場所:きゅりあん(品川区立総合区民会館)(東京都品川区)
http://bokin-nenji.sakura.ne.jp/newpage1.html
======================================================================
編集後記
======================================================================
暑い日が続いていますが、皆様いかがお過ごしでしょうか。近年よく耳にす
る「猛暑日」、これは2007年4月1日に行われた予報用語改正の際にできた言葉
で、最高気温が35度以上の日を指すそうですね。この言葉ができる以前は「酷
暑」という言葉で暑さを表現していたそうですが、「猛暑」も「酷暑」も言葉
を見ただけで「あちぃ~~~~~~」と逃げ出したくなります。私が小学生の
頃は、暑いといっても「真夏日(最高気温が30度以上)で済んでいたような。
(年齢がばれます?)「暑さ寒さも彼岸まで」とは言いますが、お彼岸が過ぎ
ると今度は残暑が・・・。早く冬が来てほしいと願う今日この頃です?!(SK)
◆◇◆ ━━━━━━━━━━━━━━━━━━━━━━━━━━━ ◆◇◆
・NBRCニュースは配信登録いただいたメールアドレスにお送りしております。
万が一間違えて配信されておりましたら、お手数ですが、下記のアドレスに
ご連絡ください。
・ご質問、転載のご要望など、NBRCニュースについてのお問い合わせは、下記
のアドレスにご連絡ください。
・掲載内容は予告なく変更することがございます。掲載内容を許可なく複製・
転載されることを禁止します。
・偶数月の1日(休日の場合はその前後)に配信しております。第17号は10月
1日に配信予定です。
編集・発行
独立行政法人製品評価技術基盤機構(NITE)バイオテクノロジーセンター
NBRCニュース編集局(nbrcnews@nite.go.jp)
◆◇◆ ━━━━━━━━━━━━━━━━━━━━━━━━━━━ ◆◇◆